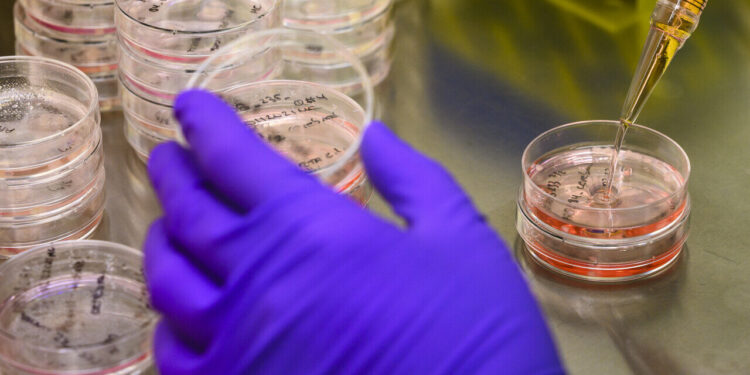
New antibodies against Klebsiella pneumoniae identified

Department of Medical Microbiology at UMC Utrecht. Credit: University Medical Center Utrecht
Researchers at UMC Utrecht have identified 29 new antibodies against the bacterium Klebsiella pneumoniae, a major cause of drug-resistant infections. Using genetic and functional approaches, the researchers have also managed to understand how these antibodies interact with antigens on the bacterial surface. Finally, they discovered that some of these new antibodies act synergistically to neutralize this pathogen.
The growing problem of antimicrobial resistance (AMR) urgently requires the development of alternative therapies against bacterial infections. One promising strategy is to boost the immune system with antibodies, either indirectly through vaccination or directly through therapeutic antibodies.
One of the main mechanisms by which antibodies can kill bacteria is by exploiting the activation of the complement system upon binding to bacterial surface antigens. Activation of the complement cascade can lead to the killing of bacteria through the insertion of large pores in the cell membrane as well as through phagocytosis.
However, the exact manner in which complement-mediated antibody-mediated bacterial killing occurs remains poorly understood. Furthermore, new tools are needed to identify antibacterial antibodies and to thoroughly study how these antibodies interact with bacterial surface structures.
Professor Suzan Rooijakkers and her colleagues from the Department of Medical Microbiology at UMC Utrecht have developed an innovative approach to identify new antibacterial antibodies from human memory B cells. The article is published in the journal Nature Communications.
New antibodies identified
While it is common to stain B cells with purified antigens, the researchers decided to take a more holistic approach and stain the B cells with whole live bacteria, thus preserving the antigens in their natural context. Using this approach, they were able to identify 29 unique antibodies against the opportunistic human pathogen Klebsiella pneumoniae, a major cause of hospital-acquired infections with increasing antimicrobial resistance.
The researchers revealed that specific antigens on the bacterial surface determined the antibody’s ability to activate complement and kill bacteria. In addition, analyses of antibody mixtures revealed that some antibodies acted synergistically by strengthening each other’s binding to the bacterial surface.
Suzan Rooijakkers, principal investigator and professor of microbiology at UMC Utrecht, concluded: “We believe that our new approach will accelerate the discovery of monoclonal antibodies against bacterial pathogens. Furthermore, our work will stimulate the field to explore whether antibody combinations are a promising avenue to develop effective antibody-based therapies against problematic infections.”
More information:
Sjors PA van der Lans et al, B cell agnostic selection approach identifies antibodies against K. pneumoniae that synergistically stimulate complement activation, Nature Communications (2024). DOI: 10.1038/s41467-024-52372-9
Provided by University Medical Center Utrecht
Quote: New antibodies against Klebsiella pneumoniae identified (2024, September 26) retrieved September 26, 2024 from
This document is subject to copyright. Apart from any fair dealing for the purpose of private study or research, no part may be reproduced without written permission. The content is provided for informational purposes only.